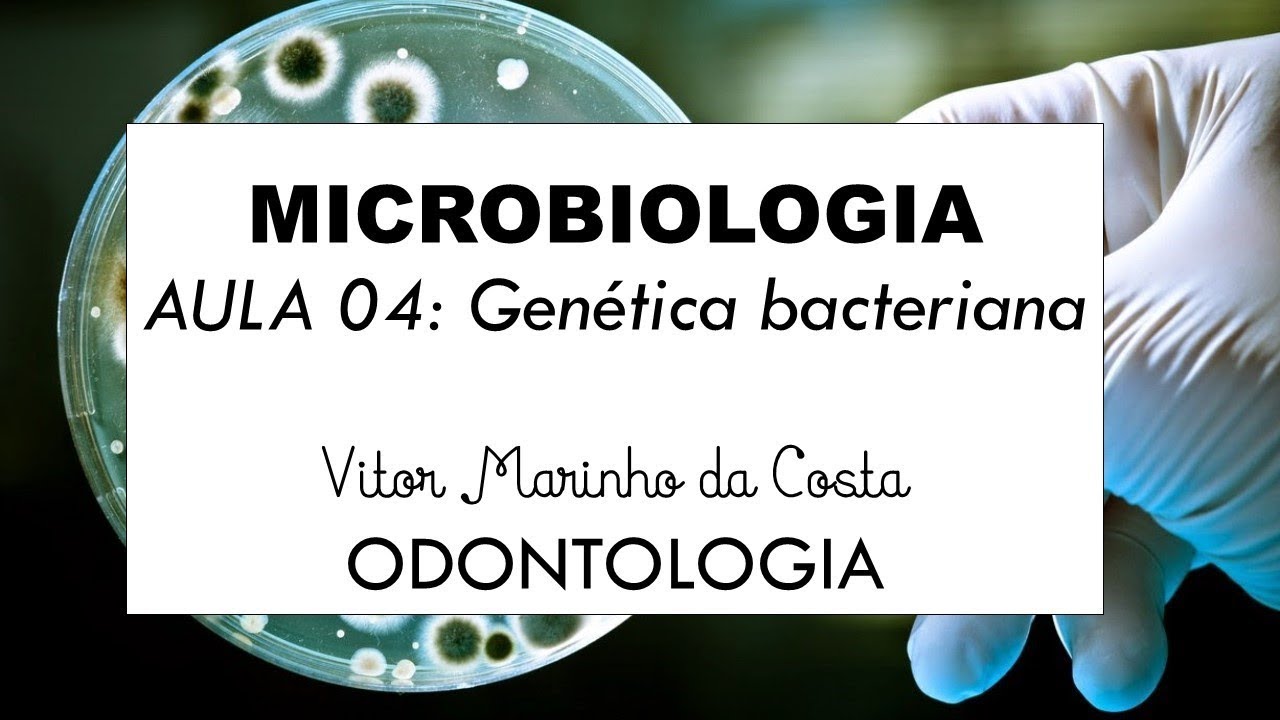
AULA 04   Genética bacteriana PARTE II

مرحبًا! مرحبًا بكم في مناقشة موضوع آخر متعلق بعلم الأحياء الدقيقة. اليوم ، سنتحدث عن الجينات البكتيرية والعمليات التي تشارك في تغيير الحمض النووي للبكتيريا.
لنبدأ؟ إن عملية "التطور البيولوجي" لكل كائن حي هي نتاج تغييرات في مادته الجينية. يتم ترميز المعلومات الواردة في هذه المادة في الغالبية العظمى من الكائنات عن طريق الحمض النووي الريبي منقوص الأكسجين - DNA. هذا جزيء ضخم على شكل خيط مزدوج دائري ، معبأ للغاية ومطوي ليبقى داخل الخلية.
يتم التحكم في جميع الخصائص الميكروبية عن طريق الوراثة ، مثل: التشكل ، الخصائص الهيكلية ، التمثيل الغذائي ، قدرة الخلية البكتيرية على الحركة ، القدرة على التفاعل مع الكائنات الحية الدقيقة الأخرى ، بالإضافة إلى القدرة على البقاء على قيد الحياة في مختلف الظروف البيئية. تحدث التغييرات في الحمض النووي البكتيري من خلال العمليات التالية: الطفرة وإعادة التركيب والحمض النووي المؤتلف. فيما يتعلق بالطفرات ، فهذه تغييرات في تسلسل قواعد الحمض النووي الموجودة في جينوم الكائن الحي التي تسببها عوامل فيزيائية أو عوامل كيميائية تسمى المطفرات.
الكائنات الحية المعرضة لعمل هذه العوامل تسمى المسوخ. تعتبر الطفرات مصادر للتنوع الجيني الكبير وبدونها ، لن تكون عملية تكيف البكتيريا ممكنة أن يحدث تغيير الحمض النووي دون الحصول على جينات من كائن دقيق آخر. في هذه الرسوم المتحركة يمكننا أن نرى كيف تتفاعل جزيئات المضادات الحيوية مع الحمض النووي البكتيري.
عندما يحدث هذا ، يتم تدمير الحمض النووي وبالتالي أيضًا الخلية التي تضمه. يحدث أنه بمرور الوقت مع الاستخدام المستمر لهذه الأدوية ، يخضع الحمض النووي للبكتيريا لعملية طفرة ، مما يتسبب في أن تصبح البكتيريا مقاومة لذلك المضاد الحيوي المحدد. في عملية إعادة التركيب الجيني ، يضمن هذا إمكانية وجود مجموعات مختلفة من الجينات من خلال نقل الحمض النووي من خلية مانحة إلى خلية متلقية ، وبالتالي المساهمة في التنوع الجيني لمجموعة بكتيرية معينة.
في عملية إعادة التركيب ، يحدث التغيير في التركيب الوراثي من خلال اكتساب الجينات من كائن دقيق آخر ، والذي لم يحدث في عملية الطفرة. الآليات التي تسمح بإعادة التركيب هي: التحول والتحول والاقتران. في عملية التحول ، يحدث النقل الجيني عندما يتم دمج الحمض النووي الحر الموجود في الوسط في المادة الوراثية لخلية متلقية ، وبالتالي تعزيز التغييرات الجينية في هذه الخلية.
في عملية التنبيغ ، يتم نقل الحمض النووي البكتيري من خلية مانحة إلى خلية متلقية عن طريق فيروس يصيب البكتيريا (العاثية أو العاثية). في عملية الاقتران ، تتضمن آلية نقل المعلومات الجينية هذه الاتصال بين خليتين. الاقتران عبارة عن آلية مشفرة بالبلازميد يتم فيها تبادل العديد من الجينات ، مثل مقاومة المضادات الحيوية ، بين البكتيريا من خلال هياكل تسمى pili.
أخيرًا ، سنتحدث عن تقنية الحمض النووي المؤتلف. أدى تطوير تقنيات البيولوجيا الجزيئية المختلفة إلى فتح حقبة جديدة عُرفت باسم الهندسة الوراثية. تعتمد الهندسة الوراثية على استنساخ العديد من الجينات ذات الأهمية.
في هذه التقنية ، يجب إدخال جزء الحمض النووي الذي يحتوي على الجين المراد استنساخه في البلازميد لإنتاج ما نسميه جزيء الحمض النووي المؤتلف. يعمل البلازميد كناقل ، أي وسيلة نقل تحمل الجينات داخل الخلية المضيفة ، وعادة ما تكون بكتيريا. داخل البكتيريا سوف يتكاثر البلازميد ، وبالتالي ينتج نسخًا من الجين المعني.
الأهداف الرئيسية لهذا الفرع من علم الأحياء هي: تطوير اللقاحات ، وتطوير العلاجات الجينية ، وتطوير الجينات المعدلة وراثيا ، سواء كانت نباتية أو حيوانية مقاومة للآفات أو المزيد من المنتجات ، وتطوير الأدوية ، والتشخيص الطبي وتكنولوجيا الطب الشرعي ، على سبيل المثال: للجرائم والأبوة. حسنًا يا رفاق ، هذا ما أردت أن أتحدث إليكم عنه. وإذا أعجبك الفيديو ، فالرجاء ترك إبهام لأعلى والاشتراك في قناتنا.
آمل أن أراك في الفرصة القادمة. حتى وقت لاحق!